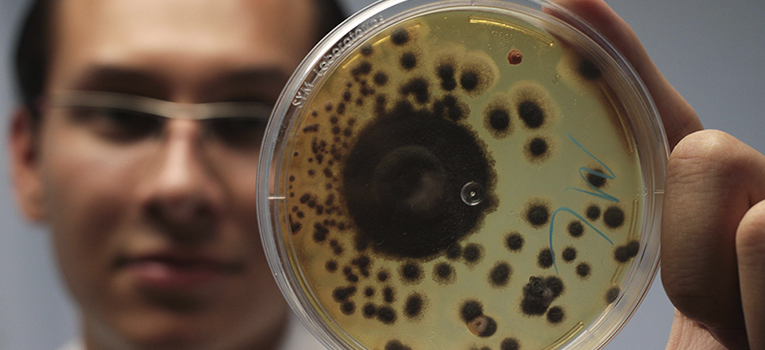
feria-ug-ugto
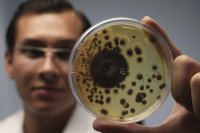

Guanajuato, Gto., September 23, 2019.- The University of Guanajuato will show the potential it has to serve the industrial sector at the Hannover Fair 2019, an event that will be held in the city of León from October 9 to 11.
This fair has been held in Germany since 1947, and on this occasion, the state of Guanajuato was chosen to be the venue, specifically the city of León. The event allows companies and exhibitors to promote services and all the potential they have, explained the General Coordinator of Ecosystem Liaison, Innovation, Development and Application of Knowledge (VIDA UG), Dr. Jesús Martínez Patiño.
In this regard, it detailed that the event will be focused on Industry 4.0 and is expected to attend about 10 thousand entrepreneurs from Mexico and abroad; about 160 exhibitors will participate, including the University of Guanajuato.
The General Coordinator of VIDA UG highlighted the vision of State Governance in managing the city of León to be the headquarters and emphasized that it represents an important opportunity for the University of Guanajuato to show its talent and strengthen links with the business sector.
Fundamentally, four axes will be sought: First, human capital. "The companies that are settling in the region are looking for top-notch talent and the University has it," said Dr. Martínez Patiño.
It also seeks to demonstrate the leadership of the UG in the field of scientific research. In addition to the basic and applied science that has positioned the Institution as a benchmark in generating new knowledge, it is intended to publicize the infrastructure available to solve the problems of companies --specifically in the industrial sector--.
The Hanover Fair will also promote the UG's Office of Technology Transfer, which is recognized by the National Council of Science and Technology (Conacyt).
Dr. Martínez Patiño explained that the third strength to be promoted at the Hannover fair is the interculturality and level of internationalization that the House of Studies has achieved. An example of this is the numerous collaboration agreements signed with various countries of the world, the extensive network of academic collaboration; projects such as the UG INNOVA Technopark, the Interinstitutional Energy Center of the University of Guanajuato (CINERGIA UG) or the VIDA UG Medical Services Tower.
Finally, Dr. Martínez Patiño mentioned that the UG's participation in the Hannover Fair in León is articulated by the VIDA UG Ecosystem, but areas such as the Department of Student Development, the Department of Research Support and the Graduate ; the Department of International Relations and Academic Cooperation and all the strengths of the four university campuses and the High School College.
Photo gallery